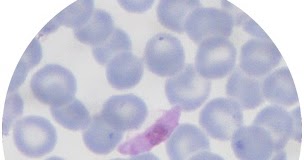

Изображения возбудителя малярии Plasmodium falciparum и последствия болезни

Раздел: Визуальные афоризмы